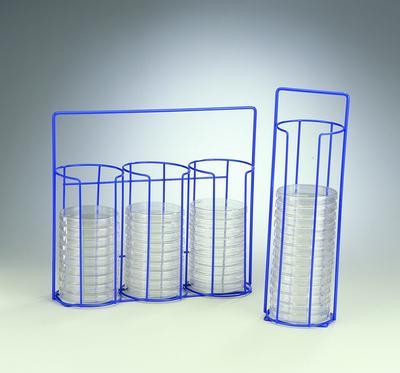

Petri Dish Carry Rack Poxygrid -20 Dish ,Each
$ 122.85
|
|
Details:
Rack^ Petri Dish Rack, Single Stack, For 100-mm diameter dishes, Epoxy-coated steel wire rack has a wide front opening that permits easy access but prevents dishes from sliding out.
Additional Information
| SKU | 23901262 |
|---|---|
| UOM | EACH |
| UNSPSC | 41122101 |
| Manufacturer Part Number | H18978-0000 |
| Product Dimensions | 4.4X13.9X3.7 Inches |
| Product Weight | 0.45 |
